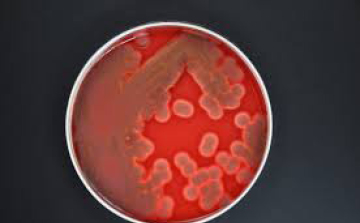
Nébih: baktérium okozta a kondorosi megbetegedéseket

Hírek

2014. November 12. 12:06, szerda |
GVH: megtévesztő hirdetések miatt 10 milliós bírság a TV Brands-nek
Megtévesztő hirdetések miatt 10 millió forintra bírságolta a TV Brands Kft.-t a Gazdasági Versenyhivatal (GVH) - közölte a versenyhatóság szerdán az MTI-vel.

2014. November 12. 12:04, szerda |
MNB: szigorúbb pénzmosás elleni szabályok januártól

2014. November 12. 12:01, szerda |
Eduline: a Semmelweis Egyetem vezeti az idei felsőoktatási rangsort

2014. November 12. 11:57, szerda |
Rövidpályás úszó-vb - Huszonegy fős magyar csapat, Cseh nélkül
Kiss László szövetségi kapitány előterjesztése nyomán 21 fős magyar úszócsapat vehet részt a december 3. és 7. között sorra kerülő dohai rövidpályás világbajnokságon.

2014. November 12. 11:45, szerda |
Erre is jó a Facebook! Megtalálta 9 éve eltűnt férjét – mégsem örült
2005-ben látta utoljára férjét az amerikai Karen Marx, aki végül rátalált a Facebookon az eltűnt férfira. Igaz dupla meglepetés érte, mivel a rábukkanás mellett kiderült, férje újra megnősült – bár el sem vált tőle.

2014. November 12. 11:21, szerda |
Saját autója nyomta át a falon és túlélte - VIDEÓ
A brazíliai Itápolisban vette fel egy utcai kamera, amint egy férfi garázsba áll autójával, majd rövid időn belül a sofőr kijön, de után nagy lendülettel érkezik az autó is.

2014. November 12. 10:42, szerda |
IEA: százmilliárd dollárba kerül a régi atomreaktorok leállítása

2014. November 12. 10:10, szerda |
A korkedvezmény meghosszabbítását kezdeményezik a mozdonyvezetők

2014. November 12. 10:09, szerda |
Több mint 8 millió forintot költött kutyája keresésére egy amerikai nő
Egy év alatt 35 ezer dollárt (8,6 millió forint) költött egy amerikai nő elveszett kutyája keresésére.

2014. November 12. 09:30, szerda |
Egy év szabadságot adományoztak munkatársai egy francia buszvezetőnek
Egy évnyi szabadnapot adományoztak egy súlyosan beteg és várandós feleségét ápoló buszvezetőnek munkatársai a franciaországi Nizzában.

2014. November 12. 06:00, szerda |
Lezárt hitel után is követel a bank – Mit tehetünk?
Egy lezárt hitel után többször is felszólítást kapott bankjától az onlinejogsebesz.hu szakértői rovat kérdezője. Természetesen kérdése, hogy ebben az ügyben, mit tehet?! Ne feledje, joga van kérdezni!

2014. November 12. 06:00, szerda |
Beszéled a szeretet-nyelvét?
Annyi módon kifejezhetjük másik iránti szerelmünket, szeretetünket ahogyan csak szeretnénk. De vajon megfelelő módját választjuk? Most ez is kiderül!